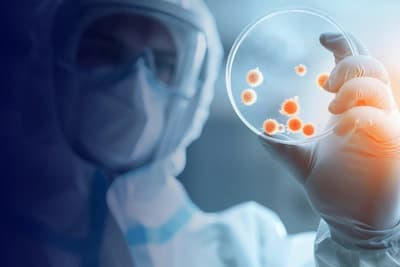
Imagem

EXTENSÃO - EAD

Verificando autenticação...
e lidere processos seguros, eficientes e em conformidade do pré ao pós-analítico
Verificando autenticação...
Verificando autenticação...

Verificando autenticação...
.
Verificando autenticação...
Aguardamos a definição do(a) coordenador(a) responsável por este curso.

Aguardamos a definição do(a) coordenador(a) responsável por este curso.

Verificando autenticação...
Apresentação:
Este curso é destinado a todas as pessoas que desejam aprofundar seus conhecimentos sobre a temática abordada. Se você busca entender melhor o assunto, explorar novas perspectivas ou aprimorar suas habilidades na área, este curso fornecerá as informações e recursos necessários para que você alcance seus objetivos. Ideal tanto para iniciantes quanto para aqueles que já possuem alguma experiência e desejam expandir seu entendimento sobre o tema.
Público: Qualquer profissional que queira atualizar seu conhecimento sobre o assunto.
Ao obter a frequência mínima de 75%, o certificado digital será expedido.
Atenção! O curso ficará disponível por 120 dias, o mesmo possui emissão de certificado.
Apresentação:
Este curso é destinado a todas as pessoas que desejam aprofundar seus conhecimentos sobre a temática abordada. Se você busca entender melhor o assunto, explorar novas perspectivas ou aprimorar suas habilidades na área, este curso fornecerá as informações e recursos necessários para que você alcance seus objetivos. Ideal tanto para iniciantes quanto para aqueles que já possuem alguma experiência e desejam expandir seu entendimento sobre o tema.
Público: Qualquer profissional que queira atualizar seu conhecimento sobre o assunto.
Ao obter a frequência mínima de 75%, o certificado digital será expedido.
Atenção! O curso ficará disponível por 120 dias, o mesmo possui emissão de certificado.
Verificando autenticação...
Nossa equipe é formada por especialistas renomados com ampla experiência acadêmica e prática. Eles estão aqui para orientar, inspirar e transformar sua trajetória profissional.
Verificando autenticação...
Na USCS, você encontra um ambiente acadêmico preparado para transformar conhecimento em prática. Nossa proposta é oferecer uma formação de qualidade, com professores experientes, infraestrutura moderna e metodologias que acompanham as demandas do mercado.
Aqui, o estudante é incentivado a desenvolver senso crítico, ampliar suas habilidades e construir uma trajetória sólida, tanto profissional quanto pessoal. Valorizamos a inovação, a pesquisa e a troca de experiências, criando oportunidades para que cada aluno possa explorar seu potencial ao máximo.
Estudar na USCS é investir em aprendizado contínuo, crescimento e novas possibilidades para o futuro.
Verificando autenticação...
Se preferir, entre em contato diretamente com nosso time de vendas pelo número (11) 2714-5699 ou clicando no ícone de WhatsApp a seguir:
CONTATO NO WHATSAPPVerificando autenticação...
Trabalhamos ao lado de grandes instituições e marcas que compartilham do mesmo propósito: oferecer qualidade, inovação e oportunidades para transformar vidas.
Verificando autenticação...
Verificando autenticação...